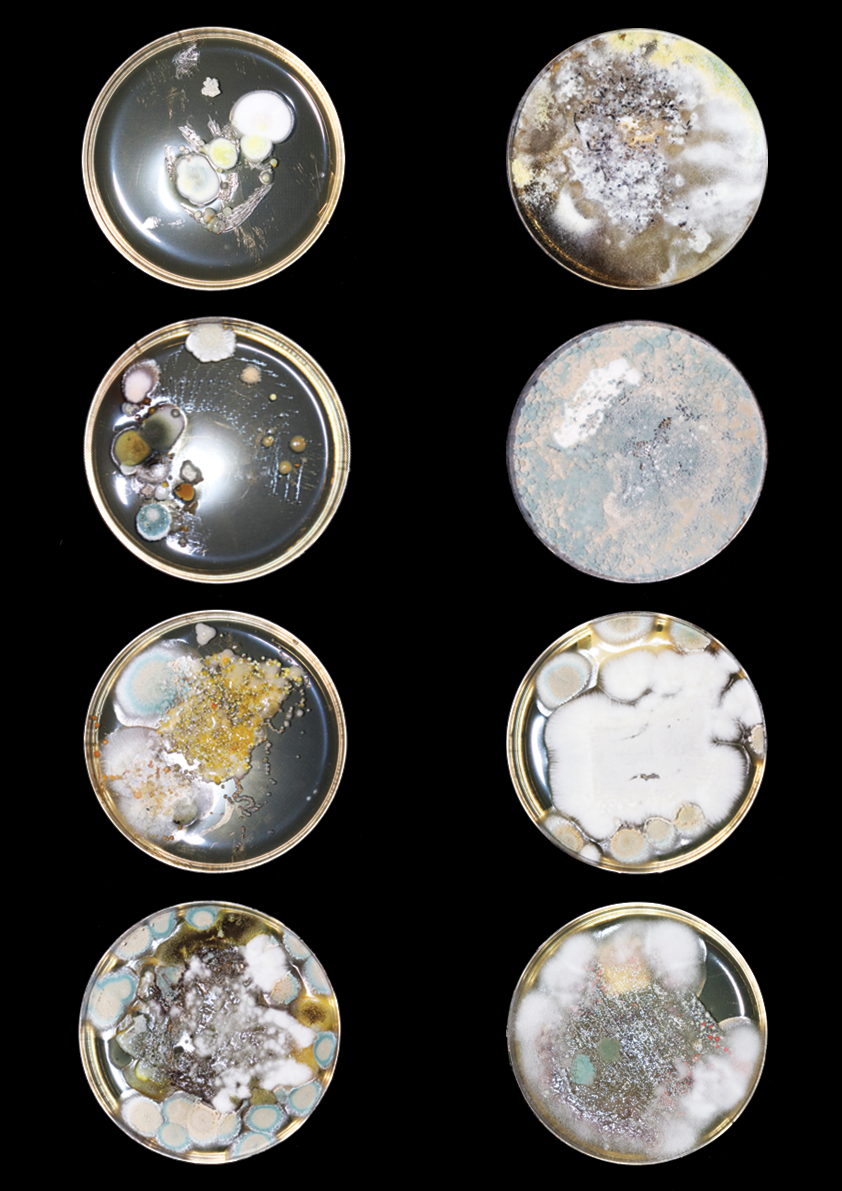

Fungi
//
Fungi //
The beauty of post-mortem.
Mould is life in slow motion — a soft bloom of time itself. On forgotten fruit or damp wood, it spreads in quiet constellations, each spore a tiny universe of persistence. Its colours — silvery blues, deep greens, ghostly whites — shimmer with the strange elegance of nature reclaiming what it once gave. In its quiet work of transformation, mould reveals that even decay can create something intricate, delicate, and unexpectedly beautiful.






Building on this, I drew directly from the visual and tactile qualities of mould to develop a series of material experiments. I began by growing my own cultures on petri dishes and documenting the subtle variations in colour, density and edge conditions. These observations informed a set of ceramic glaze tests in which I layered and mixed different glazes, allowing them to react, bleed and pool in unpredictable ways to echo the speckled, blooming effects of mould.
In parallel, I translated these patterns into textiles through embroidery and hand-punched carpet samples. By varying punch depths, thread thickness and embroidery techniques, I tried to capture the soft gradients, clustered growths and delicate transitions I had seen in the petri dishes. Across both ceramics and textiles, the aim was to transform the overlooked aesthetics of decay into nuanced surfaces that hold complexity, softness and a quiet sense of movement.